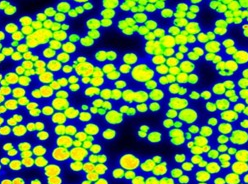
圖片關(guān)鍵詞

用途:FC 2000-Z熒光動(dòng)態(tài)顯微成像系統(tǒng)是一款功能強(qiáng)大的植物顯微熒光研究設(shè)備。該系統(tǒng)拓展了葉綠素動(dòng)態(tài)熒光成像或者多光譜熒光成像,可對(duì)單個(gè)細(xì)胞或亞細(xì)胞結(jié)構(gòu)進(jìn)行研究。常規(guī)熒光參數(shù)都可以精確到微米,進(jìn)而對(duì)植物個(gè)體甚至葉綠素顆粒進(jìn)行測量研究。
FC 2000-Z熒光動(dòng)態(tài)顯微成像系統(tǒng)使熒光成像技術(shù)真正成為光合作用機(jī)理研究的探針,使科研工作者在細(xì)胞和亞細(xì)胞層次深入理解光合作用過程及該過程中發(fā)生的各種變化,為直接研究葉綠體中光合系統(tǒng)的工作機(jī)理提供了有力的工具。

特點(diǎn):
·每幀曝光時(shí)間10 μs to 20 ms;
·10個(gè)或3個(gè)光源發(fā)射模塊產(chǎn)生測量和光化光;
·多重?zé)晒獬上瘢?/p>
·配置專業(yè)生物熒光物鏡,清晰觀察亞細(xì)胞結(jié)構(gòu)及其發(fā)出的熒光;
·內(nèi)置多種葉綠素?zé)晒鉁y量程序,如Fv/Fm,Kautsky誘導(dǎo)效應(yīng),淬滅分析,OJIP光響應(yīng)曲線,GFP等穩(wěn)態(tài)熒光,QA再氧化(可選)等,得到50多個(gè)參數(shù);
·高靈敏度CCD相機(jī),時(shí)間分辨率50幀/s,快速捕捉熒光過程;
·測量結(jié)果多樣化,有數(shù)據(jù)、圖表、圖像等;

應(yīng)用領(lǐng)域:
·活體測量植物熒光動(dòng)態(tài)成像;
·細(xì)胞和亞細(xì)胞級(jí)別熒光成像研究
·非生物和生物脅迫檢測;
·植物對(duì)脅迫抗性或敏感性研究;
測量樣品:
·植物細(xì)胞、表皮、活體切片;
·葉綠素、類囊體等亞細(xì)胞提取液;
·綠藻、藍(lán)藻等單細(xì)胞藻類;
·含有葉綠體的原生動(dòng)物;

柵欄組織和海綿組織 細(xì)胞內(nèi)葉綠體
氣孔與葉綠體 微藻
技術(shù)參數(shù):
主體 |
可選顯微鏡 | Axio Imager M2(上下移動(dòng)),Axio Scope A1(XYZ三維移動(dòng)) |
可選光源模塊 | 10-LEDs(5個(gè)閃光燈,5個(gè)持續(xù)光照燈);3-LEDs |
可選相機(jī) | 高靈敏度相機(jī);高分辨率相機(jī) |
可選濾光片 | 葉綠素?zé)晒鉃V光片組;GFP濾光片組 |
其他可選模塊 | SM 9000光譜儀 |
測量和計(jì)算參數(shù) | FO;FM;FV;FO';FM';FV';FT;FV/FM、FV'/FM'、PhiPSII 、NPQ、qN、qP、Rfd、PAR-吸收系數(shù)等50多個(gè);GFP、DAPI、DiBAC4、SYTOX、CTC等熒光蛋白和熒光染料的成像分析;QA再氧化曲線(選配) |
光譜響應(yīng) | QE最大在540nm(~75%),400nm~700nm出轉(zhuǎn)降50% |
讀出噪音 | 小于8個(gè)電荷RMS,典型6個(gè)電荷 |
滿井容量 | 大于70000電荷 |
Bios | 可固件升級(jí) |
通訊 | USB 2.0 |
電壓范圍 | 90-240V |
光源 |
類型 | 455nm,470nm,505nm,570nm,605nm,618nm,630nm,735nm,白光或其他 |
光制 | 靜態(tài)或正弦波形 |
濾波輪 | 7位 |
高靈敏度相機(jī) |
CCD檢測器波長范圍 | 400-1000nm |
CCD格式 | 720 x 560px;可選1360 x 1024px或1280 x 1024px |
像素尺寸 | 8.6×8.3μm;可選6.45 x 6.45μm |
A/D | 12位 |
成像速率 | 50幀/s |
專業(yè)軟件 |
測量程序 | 內(nèi)置常用測量程序,用戶可自己編程新的程序 |
重復(fù)測量 | 可選重復(fù)測量模塊,實(shí)現(xiàn)長時(shí)間自動(dòng)重復(fù)測量 |
分析區(qū)域 | 自動(dòng)或手動(dòng)選定 |
分析模式 | 信號(hào)計(jì)算再平均;信號(hào)平均再計(jì)算 |
結(jié)果格式 | 數(shù)據(jù)、圖表、圖像 |
產(chǎn)地:捷克